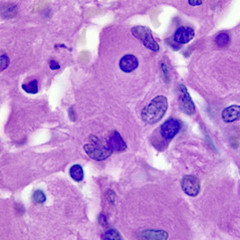
Болезнь Гоше вызывается рецессивной мутацией в гене

Воспользуйтесь поиском по сайту:
Расстройство характеризуется усталостью, анемией, низким уровнем тромбоцитов в крови, увеличением размеров печени и селезенки. Это обусловлено наследственным дефицитом фермента глюкоцереброзидазы, который действует на глюкозилцерамид жирных кислот. Когда фермент поврежден, глюкозилцерамид накапливается, в частности, в лейкоцитах, чаще всего в макрофагах (мононуклеарных лейкоцитах). Глюкозилцерамид может накапливаться в селезенке, печени, почках, легких, мозге и костном мозге.
Проявлениями болезни Гоше могут быть увеличение селезенки и печени, тяжелые неврологические осложнения, отек лимфатических узлов и прилегающих суставов, вздутие живота, коричневатый цвет кожи, анемия, низкий уровень тромбоцитов в крови и склеры.
Заболевание вызывается рецессивной мутацией в гене, расположенном на хромосоме 1, и влияет как на мужчин, так и на женщин. Примерно 1 из 100 человек в мире является носителем болезни Гоше. Болезнь названа в честь французского врача Филиппа Гоше, который первоначально описал ее в 1882 году.
Болезнь Гоше имеет три общих клинических подтипа: тип I, тип II и тип III.
Тип I является наиболее распространенной формой заболевания, встречающейся с частотой 1 на 50000 новорожденных. Симптомы болезни Гоше этого типа могут проявляться в раннем возрасте или в зрелом возрасте и включают в себя:
Тип II обычно начинает проявляться на протяжении первых шести месяцев со дня рождения и встречается с частотой примерно 1 на 100000 новорожденных. Симптомы болезни Гоше этого типа включают в себя:
Пострадавшие дети обычно умирают в возрасте 2 лет.
Тип III (хроническая нейропатическая форма) может начаться в любое время, в детстве или даже в зрелом возрасте, и встречается с частотой 1 на 100000 новорожденных. Основные симптомы включают увеличение селезенки или печени, судороги, нарушение координации, проблемы с дыханием, скелетные нарушения, нарушения движения глаз, заболевания крови, включая анемию.
Общими симптомами болезни Гоше являются:

Также лечением болезни Гоше может быть успешная трансплантация костного мозга, которая лечит не неврологические проявления болезни, так как во время процедуры вводятся моноциты с активной бета-глюкозидазой. Однако эта процедура несет значительный риск и редко рекомендуется при болезни Гоше.
Хирургическая операция по удалению селезенки (спленэктомия) требуется в редких случаях, если у пациента анемия или когда увеличенный орган влияет на здоровье больного. Переливание крови может иметь место для больных с симптомами анемии. Также в некоторых случаях требуется хирургическая замена суставов для улучшения мобильности и качества жизни.
Другие методы лечения болезни Гоше включают прием антибиотиков от инфекций, противоэпилептиков, бисфосфонатов для костных поражений, а также трансплантацию печени.
Болезнь Гоше также лечится при помощи перорального приема препаратов, которые действуют на молекулярном уровне. Миглустат является одним из этих препаратов и был одобрен для лечения болезни Гоше в 2003 году.
Видео с YouTube по теме статьи:
Информация является обобщенной и предоставляется в ознакомительных целях. При первых признаках болезни обратитесь к врачу. Самолечение опасно для здоровья!
Существуют очень любопытные медицинские синдромы, например, навязчивое заглатывание предметов. В желудке одной пациентки, страдающей от этой мании, было обнаружено 2500 инородных предметов.